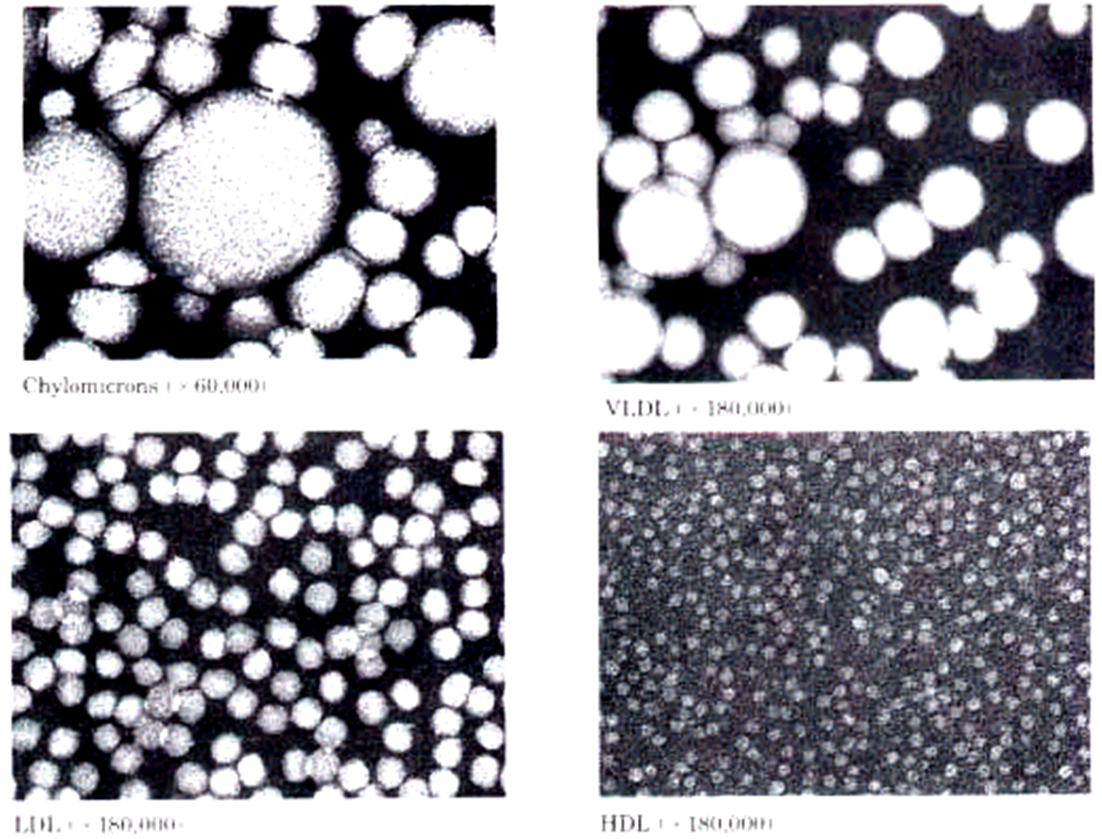
图片17.png

血浆脂蛋白的分类、组成及结构
上一节
下一节
一、血浆脂蛋白的分类
★脂蛋白特异性染料染色后电泳分离,脂蛋白可分为四个条带:
· 乳糜微粒
· β-脂蛋白
· 前 β-脂蛋白
· α-脂蛋白
(一)血浆脂蛋白的分类
★利用超速离心法可依据其密度进行分离:
· 乳糜微粒:CM,Chylomicron
· 极低密度脂蛋白(前 β):VLDL,very low density lipoprotein
· 低密度脂蛋白(β):LDL,low density lipoprotein
· 高密度脂蛋白(α):HDL,high density lipoprotein
★四种血浆脂蛋白在电镜下的形态
(二)四种血浆脂蛋白的组成

★

血浆脂蛋白的结构
★脂蛋白的外层为单层磷脂的膜,磷脂的极性基团向外,非极性基团向内
★膜上还结合有胆固醇与载脂蛋白(apolipoprotein)
★胆固醇酯与脂肪位于脂蛋白的内核
载脂蛋白的种类与功能

★血浆脂蛋白中的蛋白称载脂蛋白,apolipoprotein。
★目前已经发现了十多种载脂蛋白,分为 ApoA、ApoB、ApoC、ApoD、ApoE 五个类群。
★载脂蛋白的功能包括:
· 结合和转运脂质,稳定脂蛋白的结构
· 载脂蛋白可参与脂蛋白受体的识别
· 载脂蛋白可调节脂蛋白代谢关键酶活性


